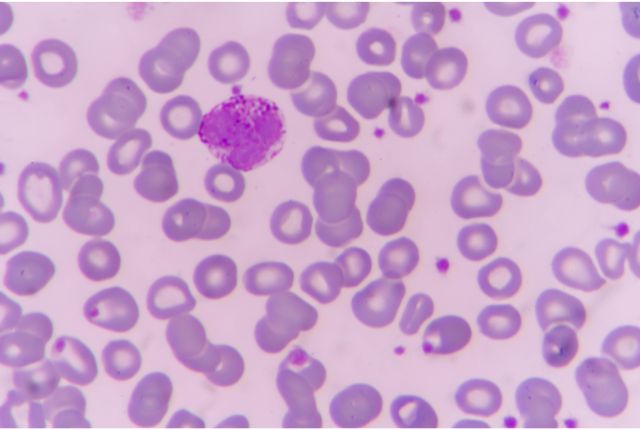

Les polynucléaires basophiles sont une catégorie particulière de globules blancs. Ils participent à la défense de l’organisme contre les bactéries et les virus. Lorsque le nombre de polynucléaires basophiles est plus bas ou plus élevé que la moyenne chez un patient, cela peut donner un indice sur son état de santé.
Définition : qu’est-ce que les polynucléaires basophiles ?
Les globules blancs, aussi appelés leucocytes, sont des cellules fabriquées par la moelle osseuse. Ils circulent dans le sang et dans les tissus lymphatiques. Leur rôle est d’aider le corps à se défendre contre les agents pathogènes extérieurs, comme les virus et les bactéries. Il existe plusieurs types de globules blancs. Parmi eux, on retrouve les polynucléaires basophiles, que l’on appelle également granulocytes basophiles. Ceux-ci représentent une toute petite part des globules blancs circulant dans le sang.
À quoi servent les polynucléaires basophiles ?
Comme les autres types de globules blancs, les polynucléaires basophiles ont pour mission de défendre l’organisme lorsque celui-ci est agressé. Ils jouent plus particulièrement un rôle dans la réponse inflammatoire. Lorsqu’une infection ou une inflammation se déclare dans le corps, les polynucléaires basophiles vont se déplacer vers la zone concernée. Ils réagissent également lorsqu’une allergie se déclare.
Quel est le taux de polynucléaires basophiles normal dans le sang ?
Les polynucléaires basophiles sont les polynucléaires les moins nombreux dans le sang. Ils représentent en effet moins de 1 % des globules blancs. Normalement, on compte moins de 100 polynucléaires basophiles par mm³ de sang. Le taux de polynucléaires basophiles normal dans le sang varie donc entre 0,01 et 0,05 G/L.
Pourquoi faire une analyse des polynucléaires basophiles ?
De nombreuses situations peuvent nécessiter un dosage des globules blancs pour en apprendre plus sur l’état de santé du patient. Cela peut être le cas lors d’un check-up de routine comme lors de la déclaration de symptômes plus précis. Dans la majorité des cas, le professionnel de santé demande un hémogramme, aussi appelé numération formule sanguine, pour avoir une analyse détaillant les quantités des différents types de cellules présentes dans le sang.
Lorsqu’une analyse sanguine permet de connaître le taux de polynucléaires basophiles dans le sang, on appelle cela une basocytémie ou une basocytose. La basocytémie est préconisée dans plusieurs cas, notamment pour aider à détecter une infection ou une allergie.
Comment se déroule un examen des polynucléaires basophiles ?
Pour réaliser le dosage de polynucléaires basophiles, un prélèvement sanguin doit être fait. Celui-ci peut être effectué au sein d’un laboratoire d’analyses biologiques.
Que signifie un taux de polynucléaires basophiles trop bas ?
Lorsque le taux de polynucléaires basophiles est inférieur à la moyenne, on parle de basocytopénie. Cette baisse du taux de polynucléaires basophiles dans le sang, qui peut même atteindre 0 % chez certains patients, peut avoir plusieurs causes. On peut par exemple l’observer dans les cas suivants :
- la soumission du patient à un stress aigu ;
- la maladie de Cushing, qui entraîne une surproduction de cortisols dans le corps ;
- l’hyperthyroïdie ;
- la prise de certains médicaments, comme des corticoïdes ;
- des réactions allergiques graves, telles qu’un choc anaphylactique ;
- l’urticaire chronique.
Que signifie un taux de polynucléaires basophiles trop élevé ?
Lorsque le taux de polynucléaires basophiles est supérieur à la moyenne, on parle de basophilie. Cette augmentation peut par exemple être remarquée dans les cas suivants :
- l’apparition d’une infection virale ;
- l’hypothyroïdie ;
- une réaction allergique ou inflammatoire comme l’asthme ou la dermatose ;
- certains types de cancers ;
- certaines maladies endocrines.
Lorsqu’une augmentation très forte du nombre de polynucléaires basophiles dans le sang est remarquée, cela peut être lié à l’une des pathologies suivantes :
- les syndromes myéloprolifératifs ;
- les syndromes myéloprolifératifs non dysplasiques ;
- les leucémies aiguës.
Dans la majorité des cas, l’augmentation ou la baisse du taux de polynucléaires basophiles dans le sang n’est pas inquiétante. Le professionnel de santé peut prescrire un nouveau dosage sanguin dans les semaines qui suivent les premiers résultats pour vérifier son évolution. Un taux anormal de polynucléaires basophiles peut cependant être un symptôme révélateur d’une maladie ou d’une allergie. Le professionnel de santé pourra notamment être alerté si d’autres cellules sanguines présentent des taux sortant de la norme. Pour retrouver un taux normal, et plus globalement se soigner, il faut avant tout traiter la pathologie associée. Pour poser un diagnostic, des examens complémentaires sont souvent nécessaires pour en apprendre plus sur l’état de santé du patient. Le médecin pourra par la suite définir le traitement le plus adapté à la pathologie dont souffre le patient.
Cet article médical a été relu et validé par un médecin spécialiste biologie médicale au sein d’un établissement ELSAN, groupe leader de l’hospitalisation privée en France. Il a un but uniquement informatif et ne se substitue en aucun cas à l’avis de votre médecin, seul habilité à poser un diagnostic.
Pour établir un diagnostic médical précis et correspondant à votre cas personnel ou en savoir davantage et avoir plus d’informations sur votre pathologie, nous vous rappelons qu’il est indispensable de prendre contact et de consulter un médecin.
Vous trouverez ci-dessous, les biologistes médicales au sein des hôpitaux privés ELSAN, qui vous reçoivent en RDV près de chez vous, dans l’un de nos établissements.
Prenez tout de suite rendez-vous !
Obtenez un rendez-vous en moins de 5 min avec l'un de nos praticiens en choisissant le créneau horaire qui vous convient le mieux dans un établissement près de chez vous !
Vos questions fréquemment posées :
Quelle est la cause de l'augmentation des basophiles ?
L'augmentation des basophiles peut être due à une infection virale, à l'hypothyroïdie, à une réaction allergique, à certaines maladies endocrines ou encore à certains cancers.
Quel taux de leucocytes est inquiétant ?
Dans la plupart des cas, l’augmentation ou la baisse du taux de polynucléaires basophiles dans le sang n’est pas synonyme de pathologies graves.
Analyses associées à la Biologie médicale
- Acide folique
- Acide urique
- Acide urique et urée : trois différences
- Albumine
- Cholestérol
- Cholestérol et triglycérides : sept différences
- Créatinine
- Protéine c réactive ou CRP
- CRP : qu’est-ce qu’une inflammation ?
- Taux de CRP pour un cancer, comment savoir s’il faut s’inquiéter ?
- Ferritine
- Gamma GT élevé
- Glycémie
- Hémoglobine
- Hémostase
- Hypoglycémie
- Leucocyturie
- Lipase
- Monocytes
- NFS, numération formule sanguine ou hémogramme
- A partir de quel taux de PSA faut-il s'inquiéter ?
- Polynucléaires basophiles
- Polynucléaires neutrophiles
- Prise de sang
- Triglycérides
- TSH
- Vitesse de sédimentation